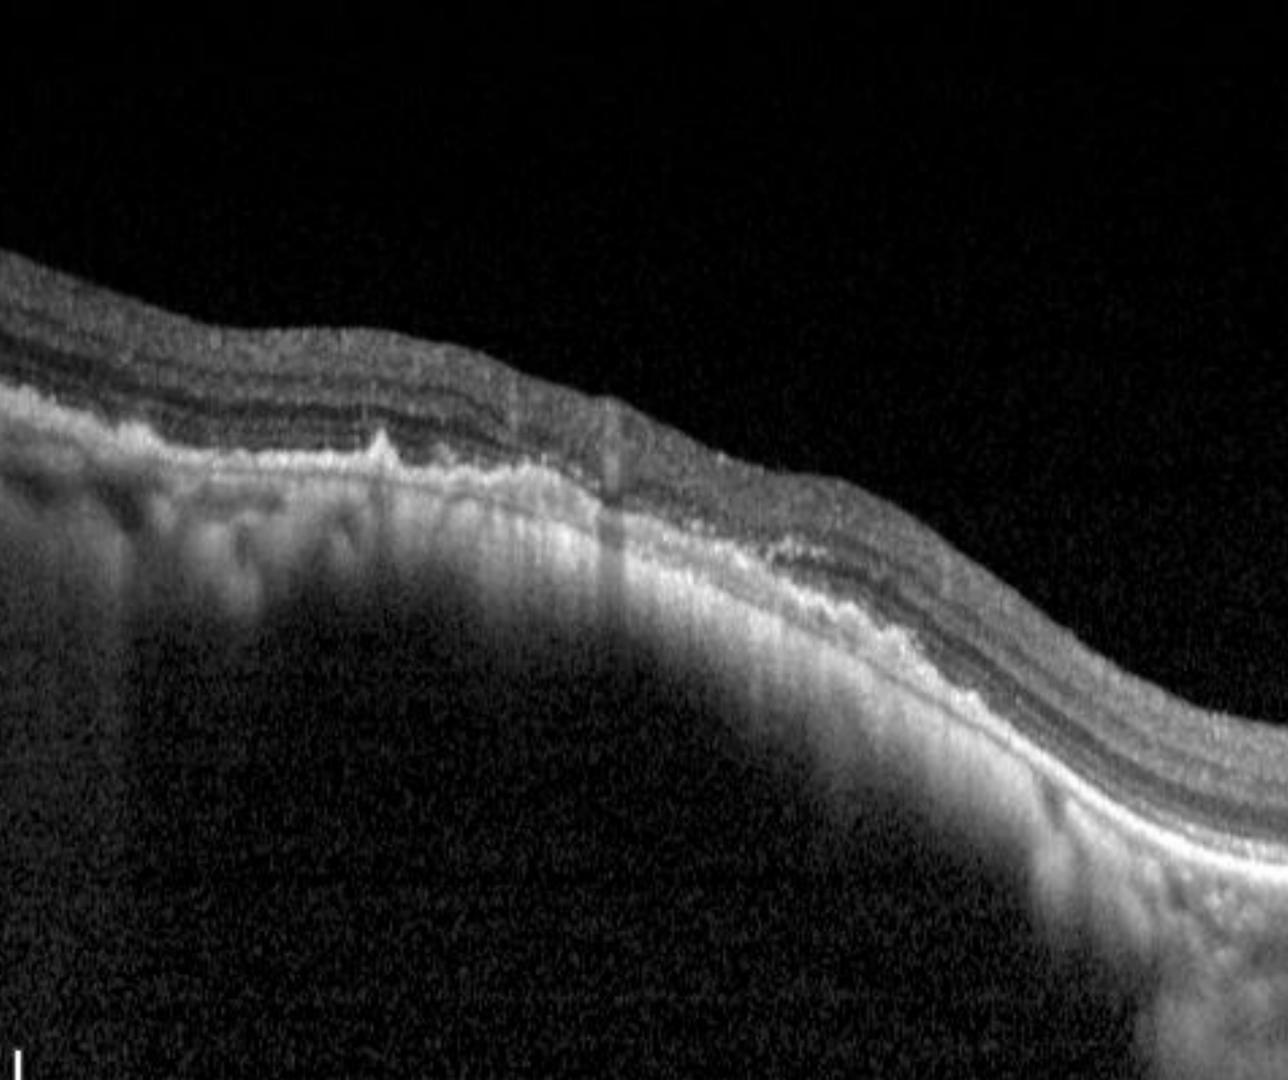

Overview
Choroidal lesions are typically most visible on red-separation (green-free) imaging but become essentially invisible on green separation (red-free) imaging. This is because red light has a longer wavelength so is absorbed by tissues deeper in the retina (the choroid) while green light is absorbed by more superficial structures and hence shows up retinal detail more effectively.
Choroidal naevi and choroidal melanoma are part of a disease spectrum and it can be difficult to distinguish between a suspicious choroidal naevus and a melanoma so referral of lesions with suspicious features to an ocular oncologist or ophthalmogist is appropriate. This resource will help users to understand the features of choroidal lesions identified in the literature as suspicious for malignancy to help inform clinical decision-making.